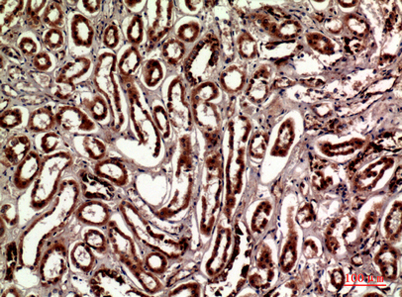

$148.00/50µL $248.00/100µL
| 50 µL | $148.00 |
| 100 µL | $248.00 |
| Product name: | Talin-1 rabbit pAb |
| Reactivity: | Human;Mouse;Rat |
| Alternative Names: | TLN1; KIAA1027; TLN; Talin-1 |
| Source: | Rabbit |
| Dilutions: | Western Blot: 1/500 - 1/2000. IHC-p: 1:100-300 ELISA: 1/20000. IF 1:100-300 Not yet tested in other applications. |
| Immunogen: | The antiserum was produced against synthesized peptide derived from the C-terminal region of human TLN1. AA range:2471-2520 |
| Storage: | -20°C/1 year |
| Clonality: | Polyclonal |
| Isotype: | IgG |
| Concentration: | 1 mg/ml |
| Observed Band: | 269kD |
| GeneID: | 7094 |
| Human Swiss-Prot No: | Q9Y490 |
| Cellular localization: | Cell projection, ruffle membrane ; Peripheral membrane protein ; Cytoplasmic side . Cytoplasm, cytoskeleton . Cell surface . Cell junction, focal adhesion . Colocalizes with LAYN at the membrane ruffles. Localized preferentially in focal adhesions than fibrillar adhesions (By similarity). . |
| Background: | This gene encodes a cytoskeletal protein that is concentrated in areas of cell-substratum and cell-cell contacts. The encoded protein plays a significant role in the assembly of actin filaments and in spreading and migration of various cell types, including fibroblasts and osteoclasts. It codistributes with integrins in the cell surface membrane in order to assist in the attachment of adherent cells to extracellular matrices and of lymphocytes to other cells. The N-terminus of this protein contains elements for localization to cell-extracellular matrix junctions. The C-terminus contains binding sites for proteins such as beta-1-integrin, actin, and vinculin. [provided by RefSeq, Feb 2009], |